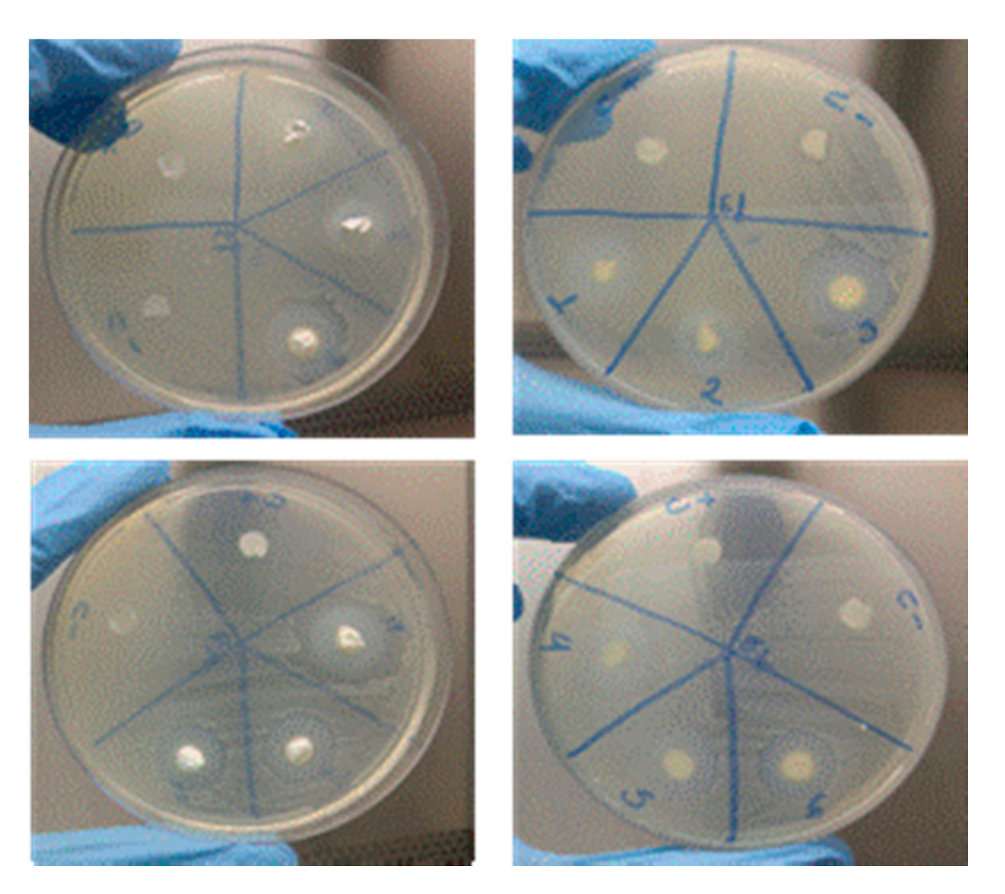
Materials 14 00488 g007 Materials 14 00488 g007

Chitosan-Based Biomaterial, Calcium Hydroxide and Chlorhexidine for Potential Use as Intracanal Medication
Abstract
1. Introduction
2. Materials and Methods
2.1. Materials
- Low molecular weight chitosan, with a deacetylation degree of approximately 90%, produced in the CERTBIO—UFCG (Campina Grande, PB, Brazil).
- Glacial Acetic Acid P.A., Sigma Aldrich® (Suzano, SP, Brazil).
- Calcium hydroxide produced at CERTBIO—UFCG.
- Polyethylene glycol 400, (PEG). Vetec (São Paulo, SP, Brazil).
- Chlorhexidine 2%, (CLX) Rioquímica (São José do Rio Preto, SP, Brazil).
2.2. Methods
2.2.1. Preparation of the Chitosan Solution
2.2.2. Calcium Hydroxide Synthesis—Ca(OH)2
2.2.3. Sample Development
2.3. Characterization
2.3.1. Fourier Transform Infrared Spectroscopy (FTIR)
2.3.2. X-ray Diffraction (XRD)
2.3.3. Rheological Measurement
2.3.4. Microbiological Analysis
Method of Agar Disk Diffusion Test
3. Results and Discussion
3.1. Fourier Transform Infrared Spectroscopy (FTIR)
3.2. X-ray Diffraction (XRD)
3.3. Rheological Measurement
3.4. Microbiological Analysis
4. Conclusions
Author Contributions
Funding
Institutional Review Board Statement
Informed Consent Statement
Data Availability Statement
Conflicts of Interest
References
- Pires, A.L.R.; Bierhalz, A.C.; Moraes, Â.M. Biomateriais: Tipos, aplicações e mercado. Química Nova 2015, 38, 957–971. [Google Scholar]
- Azevedo, V.V.C.; Chaves, S.A.; Bezerra, D.C.; Lia Fook, M.V.; Costa, A.C.F.M. Quitina e Quitosana: Aplicações como biomateriais. Rev. Eletrônica Mater. Process. 2007, 2, 27–34. [Google Scholar]
- Şenel, S.; Mc Clure, S.J. Potential applications of chitosan in veterinary medicine. Adv. Drug Deliv. Rev. 2004, 56, 1467–1480. [Google Scholar] [CrossRef] [PubMed]
- Laranjeira, M.; Fávere, V.T.D. Quitosana: Biopolímero funcional com potencial industrial biomédico. Química Nova 2009, 32, 672–678. [Google Scholar] [CrossRef]
- Tonhi, E.; Plepis, A.M.D.G. Obtenção e caracterização de blendas colágeno-quitosana. Química Nova 2002, 25, 943–948. [Google Scholar] [CrossRef]
- Silva, H.S.; dos Santos, K.S.; Ferreira, E.I. Quitosana: Derivados hidrossolúveis, aplicações farmacêuticas e avanços. Química Nova 2006, 29, 776–785. [Google Scholar] [CrossRef]
- Tavaria, F.K.; Costa, E.M.; Pina-Vaz, I.; Carvalho, M.F.; Pintado, M.M. A quitosana como biomaterial odontológico: Estado da arte. Rev. Bras. Eng. Biomédica 2013, 29, 110–120. [Google Scholar] [CrossRef][Green Version]
- Cheung, R.C.F.; Ng, T.B.; Wong, J.H.; Chan, W.Y. Chitosan: An update on potential biomedical and pharmaceutical applications. Mar. Drugs 2013, 13, 5156–5186. [Google Scholar] [CrossRef]
- Bramante, M.; Hungaro, M.A.; Duarte, M.R.; Aouada, A.K. Chelating and antibacterial properties of chitosan nanoparticles on dentin. Restor. Dent. Endod. 2015, 40, 195–201. [Google Scholar]
- El-Sherbiny, I.; Salih, E.; Reicha, F. New trimethyl chitosan-based composite nanoparticles as promising antibacterial agents. Drug Dev. Ind. Pharm. 2016, 42, 720–729. [Google Scholar] [CrossRef]
- Soares, D.G.; Rosseto, H.L.; Basso, F.G.; Scheffel, D.S.; Hebling, J.; Costa, C.A.D.S. Chitosan-collagen biomembrane embedded with calcium-aluminate enhances dentinogenic potential of pulp cells. Braz. Oral Res. 2016, 30, 1–10. [Google Scholar] [CrossRef] [PubMed]
- Aksel, H.; Mahjour, F.; Bosaid, F.; Calamak, S.; Azim, A.A. Antimicrobial Activity and Biocompatibility of Antibiotic-Loaded Chitosan Hydrogels as a Potential Scaffold in Regenerative Endodontic Treatment. J. Endod. 2020, 46, 1867–1875. [Google Scholar] [CrossRef] [PubMed]
- Ruksakiet, K.; Hanák, L.; Farkas, N.; Hegyi, P.; Sadaeng, W.; Czumbel, L.M.; Sang-ngoen, T.; Garami, A.; Mikó, A.; Varga, G.; et al. Antimicrobial efficacy of chlorhexidine and sodium hypochlorite in root canal disinfection: A systematic review and meta-analysis of randomized controlled trials. J. Endod. 2020, 46, 1032–1041. [Google Scholar] [CrossRef] [PubMed]
- Ferreira, R.; Santos, R.; Wagner, M.; Dotto, S.R.; Travassos, R.M.C. Avaliação da ação antimicrobiana de diferentes medicações usadas em endodontia. Rev. Odonto Ciênc. 2006, 21, 266–269. [Google Scholar]
- Ballal, N.V.; Shavi, G.V.; Kumar, R.; Kundabala, M.; Bhat, K.S. In vitro sustained release of calcium ions and pH maintenance from different vehicles containing calcium hydroxide. J. Endod. 2010, 36, 862–866. [Google Scholar] [CrossRef]
- Pereira dos Santos, E.; Nicácio, P.H.M.; Coêlho Barbosa, F.; Nunes da Silva, H.; Andrade, A.L.S.; Lia Fook, M.V.; de Lima Silva, S.M.; Farias Leite, I. Chitosan/essential oils formulations for potential use as wound dressing: Physical and antimicrobial properties. Materials 2019, 12, 2223. [Google Scholar] [CrossRef]
- Lacerda-Santos, R.; de Morais Sampaio, G.A.; de Fátima Liberato de Moura, M.; de Carvalho, F.G.; dos Santos, A.; Melo Pithon, M.; Muniz Alves, P. Effect of Different Concentrations of Chlorhexidine in Glass-ionomer Cements on In Vivo Biocompatibility. J. Adhes. Dent. 2016, 18, 325–330. [Google Scholar]
- Da Silva, L.; Finer, Y.; Friedman, S.; Basrani, B.; Kishen, A. Biofilm formation within the interface of bovine root dentin treated with conjugated chitosan and sealer containing chitosan nanoparticles. J. Endod. 2013, 39, 249–253. [Google Scholar] [CrossRef]
- Telles, Í.S.F. Produção, Caracterização e Avaliação de nano e Micropartículas de ácido Ascórbico Para Fins Odontológicos. Master’s Thesis, Universidade Federal do Rio de Janeiro, Rio de Janeiro, Brazil, 2018; pp. 65–70. [Google Scholar]
- Soares, D.G.; Anovazzi, G.; Bordini, E.A.F.; Zuta, U.O.; Leite, M.L.A.S.; Basso, F.G.; Hebling, J.; de Souza Costa, C.A. Biological analysis of simvastatin-releasing chitosan scaffold as a cell-free system for pulp-dentin regeneration. J. Endod. 2018, 44, 971–976. [Google Scholar] [CrossRef]
- Almutairi, W.; Yassen, G.H.; Aminoshariae, A.; Williams, K.A.; Mickel, A. Regenerative endodontics: A systematic analysis of the failed cases. J. Endod. 2019, 45, 567–577. [Google Scholar] [CrossRef]
- Holanda, A.L.D. Membranas de Quitosana Para Uso em Sistema de Liberação Controlada de Insulina: Síntese e Caracterização. Master’s Thesis, Universidade Federal de Campina Grande, Campina Grande, Brazil, 2011; pp. 1–113. [Google Scholar]
- Sousa, W.J.B.D. Desenvolvimento de Filmes Híbridos de Quitosana/Fosfato de Cálcio Com Incorporação de Vitamina E. Master’s Thesis, Universidade Federal de Campina Grande, Campina Grande, Brazil, 2012; pp. 1–98. [Google Scholar]
- Guerrero, L.C.; Garza-Cervantes, J.; Caballero-Hernández, D.; González-López, R.; Sepúlveda-Guzmán, S.; Cantú-Cárdenas, E. Synthesis and characterization of calcium hydroxide obtained from agave bagasse and investigation of its antibacterial activity. Rev. Int. Contam. Ambient. 2017, 33, 347–353. [Google Scholar] [CrossRef]
- Brugnerotto, J.; Lizardi, J.; Goycoolea, F.M.; Argüelles-Monal, W.; Desbrieres, J.; Rinaudo, M. An infrared investigation in relation with chitin and chitosan characterization. Polymer 2001, 42, 3569–3580. [Google Scholar] [CrossRef]
- Kawano, Y. Espectroscopia vibracional de absorção no infravermelho. In Técnicas de Caracterização de Polímeros; Canevarolo, S.V., Jr., Ed.; Artliber: São Paulo, Brazil, 2003; pp. 17–39. [Google Scholar]
- Kanh, H. Difração de Raios X. Apostila Técnica, PMI2201—Técnicas de Caracterização de Materiais. Escola Politécnica-USP, [sd] a. Available online: http://www.ebah.com.br/difracao-de-raio-x-pdf-a94808.html (accessed on 2 November 2019).
- Basrani, B.; Ghanem, A.; Tjäderhane, L. Physical and chemical properties of chlorhexidine and calcium hydroxide-containing medications. J. Endod. 2004, 30, 413–417. [Google Scholar] [CrossRef] [PubMed]
- Andrews, J.M. BSAC standardized disc susceptibility testing method (version 4). J. Antimicrob. Chemother. 2005, 56, 60–76. [Google Scholar] [CrossRef] [PubMed]
- Pelissari, F.M.; Grossmann, M.V.; Yamashita, F.; Pineda, E.A.G. Antimicrobial, mechanical, and barrier properties of cassava starch− chitosan films incorporated with oregano essential oil. J. Agric. Food Chem. 2009, 57, 7499–7504. [Google Scholar] [CrossRef]
- dos Santos, M.V.B.; Feitosa, G.T.; Osajima, J.A.; Santos, R.L.P.; da Silva Filho, E.C. Desenvolvimento de biomaterial composto por hidroxiapatita e clorexidina para aplicação na cavidade oral. Cerâmica 2019, 65, 130–138. [Google Scholar] [CrossRef]
- Blesa, M.J.; Miranda, J.L.; Moliner, R. Micro-FTIR study of the blend of humates with calcium hydroxide used to prepare smokeless fuel briquettes. Vib. Spectrosc. 2003, 33, 31–35. [Google Scholar] [CrossRef]
- de Sá, M.D.; dos Santos, F.S.F.; Ferreira, V.P.; Lia Fook, M.V. Análise química, térmica e morfológica de compostos de PEEK/CaCO3. Rev. Eletrônica Mater. Process. 2016, 11, 49–53. [Google Scholar]
- Shameli, K.; Bin Ahmad, M.; Jazayeri, S.D.; Sedaghat, S.; Shabanzadeh, P.; Jahangirian, H.; Mahdavi, M.; Abdollahi, Y. Synthesis and characterization of polyethylene glycol mediated silver nanoparticles by the green method. Int. J. Mol. Sci. 2012, 13, 6639–6650. [Google Scholar] [CrossRef]
- Yuan, Q.; Shah, J.; Hein, S.R.D.K.; Misra, R.D.K. Controlled and extended drug release behavior of chitosan-based nanoparticle carrier. Acta Biomater. 2010, 6, 1140–1148. [Google Scholar] [CrossRef]
- Ansari, M.; Naghib, S.M.; Moztarzadeh, F.; Salati, A. Synthesis and characterisation of hydroxyapatite-calcium hydroxide for dental composites. Ceram. Silikáty 2011, 55, 123–126. [Google Scholar]
- Dallan, P.R.M. Síntese e Caracterização de Membranas de Quitosana Para Aplicação na Regeneração de Pele. Ph.D. Thesis, UNICAMP Universidade Estadual de Campinas, Campinas, Brazil, 2005; pp. 1–194. [Google Scholar]
- Xu, Y.X.; Kim, K.M.; Hanna, M.A.; Nag, D. Chitosan–starch composite film: Preparation and characterization. Ind. Crops Prod. 2005, 21, 185–192. [Google Scholar] [CrossRef]
- Lima, R.S.C. Desenvolvimento de Sistemas de Liberação Controlada de Fármacos: Quitosana/Insulina. Ph.D. Thesis, Universidade Federal de Campina Grande, Campina Grande, Brazil, 2010; pp. 1–112. [Google Scholar]
- Luo, D.; Sang, L.; Wang, X.; Xu, S.; Li, X. Low temperature, pH-triggered synthesis of collagen–chitosan–hydroxyapatite nanocomposites as potential bone grafting substitutes. Mater. Lett. 2011, 65, 2395–2397. [Google Scholar] [CrossRef]
- Cruz, J. Arcabouços de Quitosana/Agente Antineoplásico: Síntese, Caracterização e Aplicação. Ph.D. Thesis, Universidade Federal de Campina Grande, Campina Grande, Brazil, 2015; pp. 1–114. [Google Scholar]
- Rosendo, R.A. Desenvolvimento e Caracterização de Scaffolds de Quitosana/Cissus verticillata (L.) Nicolson CE Jarvis. Ph.D. Thesis, Universidade Federal de Campina Grande, Campina Grande, Brazil, 2016; pp. 1–161. [Google Scholar]
- Khachani, M.; El Hamidi, A.; Halim, M.; Arsalane, S. Non-isothermal kinetic and thermodynamic studies of the dehydroxylation process of synthetic calcium hydroxide Ca (OH)2. J. Mater. Environ. Sci. 2014, 5, 615–624. [Google Scholar]
- Hardikar, V.V.; Matijević, E. Influence of ionic and nonionic dextrans on the formation of calcium hydroxide and calcium carbonate particles. Colloids Surf. A Physicochem. Eng. Asp. 2001, 186, 23–31. [Google Scholar] [CrossRef]
- Sébaıbi, Y.; Dheilly, R.M.; Quéneudec, M. A study of the viscosity of lime–cement paste: Influence of the physico-chemical characteristics of lime. Constr. Build. Mater. 2004, 18, 653–660. [Google Scholar] [CrossRef]
- Gao, Y.; Jiang, X.; Lin, D.; Chen, Y.; Tong, Z. The starvation resistance and biofilm formation of Enterococcus faecalis in coexistence with Candida albicans, Streptococcus gordonii, Actinomyces viscosus, or Lactobacillus acidophilus. J. Endod. 2016, 42, 1233–1238. [Google Scholar] [CrossRef]
- Fraga, E.G.; Nicodemo, A.C.; Sampaio, J.L.M. Antimicrobial susceptibility of Brazilian Clostridium difficile strains determined by agar dilution and disk diffusion. Braz. J. Infect. Dis. 2016, 20, 476–481. [Google Scholar] [CrossRef]
- Jeon, S.J.; Oh, M.; Yeo, W.S.; Galvao, K.N.; Jeong, K.C. Underlying mechanism of antimicrobial activity of chitosan microparticles and implications for the treatment of infectious diseases. PLoS ONE 2014, 9, e92723. [Google Scholar] [CrossRef]
- Lopes, H.P.; Siqueira, J.F., Jr. Medicação Intracanal. In Endodontia: Biologia e Técnica, 4th ed.; Elsevier: Rio de Janeiro, Brazil, 2015; pp. 945–989. [Google Scholar]
- Felgueiras, H.P.; Amorim, M.T.P. Functionalization of electrospun polymeric wound dressings with antimicrobial peptides. Colloids Surf. B Biointerfaces 2017, 156, 133–148. [Google Scholar] [CrossRef]
- Cohen, S.; Hargreaves, K.M. Limpeza e modelagem do sistema de canais radiculares. In Caminhos da Polpa, 7th ed.; Elsevier: Rio de Janeiro, Brazil, 2007; pp. 265–323. [Google Scholar]

| Sample | Staphylococcus Aureus ATCC 25923 | Enterococcus Faecalis ATCC 29212 |
|---|---|---|
| Diameter (mm) 24 h | Diameter (mm) 24 h | |
| M1: Ca(OH)2 +Q2% | 10 | 11 |
| M2: Ca(OH)2 +Q4% | 11 | 10 |
| M3: Ca(OH)2 +Q2%+ CLX2% | 22 | 19 |
| M4: Ca(OH)2 +Q4%+ CLX2% | 17 | 20 |
| M5: Ca(OH)2 +Q2%+ PEG | 17 | 16 |
| M6: Ca(OH)2 +Q4%+ PEG | 14 | 13 |
| (C+) NaClO 2.5% | 28 | 22 |
Publisher’s Note: MDPI stays neutral with regard to jurisdictional claims in published maps and institutional affiliations. |
© 2021 by the authors. Licensee MDPI, Basel, Switzerland. This article is an open access article distributed under the terms and conditions of the Creative Commons Attribution (CC BY) license (http://creativecommons.org/licenses/by/4.0/).
Share and Cite
Nunes, B.d.S.; Rosendo, R.A.; Filho, A.A.d.O.; Fook, M.V.L.; de Sousa, W.J.B.; Barbosa, R.C.; Pina, H.d.V.; da Silva Neto, J.E.; Amoah, S.K.S.; Fontana, C.E.; et al. Chitosan-Based Biomaterial, Calcium Hydroxide and Chlorhexidine for Potential Use as Intracanal Medication. Materials 2021, 14, 488. https://doi.org/10.3390/ma14030488
Nunes BdS, Rosendo RA, Filho AAdO, Fook MVL, de Sousa WJB, Barbosa RC, Pina HdV, da Silva Neto JE, Amoah SKS, Fontana CE, et al. Chitosan-Based Biomaterial, Calcium Hydroxide and Chlorhexidine for Potential Use as Intracanal Medication. Materials. 2021; 14(3):488. https://doi.org/10.3390/ma14030488
Chicago/Turabian StyleNunes, Bruna de Siqueira, Rosana Araújo Rosendo, Abrahão Alves de Oliveira Filho, Marcus Vinícius Lia Fook, Wladymyr Jefferson Bacalhau de Sousa, Rossemberg Cardoso Barbosa, Hermano de Vasconcelos Pina, João Emídio da Silva Neto, Solomon Kweku Sagoe Amoah, Carlos Eduardo Fontana, and et al. 2021. "Chitosan-Based Biomaterial, Calcium Hydroxide and Chlorhexidine for Potential Use as Intracanal Medication" Materials 14, no. 3: 488. https://doi.org/10.3390/ma14030488
APA StyleNunes, B. d. S., Rosendo, R. A., Filho, A. A. d. O., Fook, M. V. L., de Sousa, W. J. B., Barbosa, R. C., Pina, H. d. V., da Silva Neto, J. E., Amoah, S. K. S., Fontana, C. E., Bueno, C. E. d. S., & De Martin, A. S. (2021). Chitosan-Based Biomaterial, Calcium Hydroxide and Chlorhexidine for Potential Use as Intracanal Medication. Materials, 14(3), 488. https://doi.org/10.3390/ma14030488





